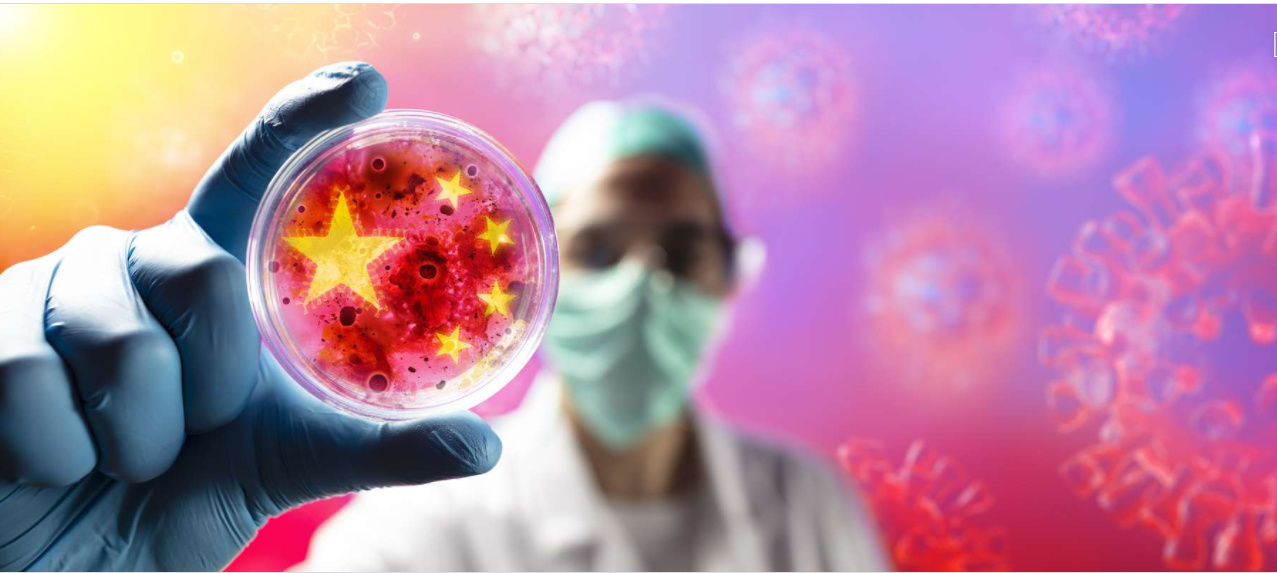

Vous n'êtes pas identifié.
• Annonce ToutSurTout
Déjà 16 ans !

Si vous souhaitez participer vous aussi aux discussions sur le forum, il faut vous inscrire ou vous identifier.
Les inscriptions sont actuellement OUVERTES.
Pages: 1
Réponse : 0 / Vues : 2 258
- Accueil forums
- » Le bar
- » Des coronavirus encore inconnus et potentiellement « très dangereux » découverts à Wuhan
Message 1 Discussion postée le 16-04-2021 à 18:14:23
El Roslino 






- Titre: VIP
- Avancement: Niveau 5
- Lieu: U.S.A
- Date d'inscription: 07-07-2016
- Messages: 33 550
- Site web
Des coronavirus encore inconnus et potentiellement « très dangereux » découverts à Wuhan
Plusieurs génomes de coronavirus proches du SARS et du MERS ont été découverts dans des universités agricoles chinoises.
Voilà qui ne va pas manquer de relancer l'hypothèse de la fuite du coronavirus d'un laboratoire. Une équipe de chercheurs a découvert dans les laboratoires des universités agricoles de Wuhan et Huazhong plusieurs génomes de coronavirus encore inconnus.
Un nouveau bétacoronavirus proche du HKU5 et étroitement lié au MERS-Cov a notamment été trouvé parmi un ensemble de données sur le coton séquencé par l'Université agricole de Huazhong en 2017. D'autres séquences de clones infectieux liés au HKU4 ainsi qu'un virus de l'encéphalite japonaise ont été identifiés dans du coton séquencé par l'Université en 2018.
Encore plus troublant : l'un des nouveaux bêtacoronavirus découverts chez une souris provient directement du Wuhan Institute of Virology, soupçonné d'être à l'origine de l'hypothétique fuite du SARS-Cov-2. « En utilisant les séquences génétiques découvertes, nous avons pu assembler des génomes complets de deux nouveaux coronavirus », dont l'un « très similaire » au virus de Nipah, alertent les chercheurs dans une étude pré-publiée sur le serveur arXiv.
« La découverte de multiples agents pathogènes humains dangereux dans des laboratoires de séquençage agricole soulève des préoccupations au sujet des violations des protocoles de biosécurité », préviennent les auteurs, qui s'inquiètent notamment des contrôles moins stricts dans les laboratoires agricoles que dans les laboratoires de virologie. Il est à espérer que les universités chinoises ont renforcé leurs protocoles depuis l'émergence du SARS-CoV-2.


Réponse : 0 / Vues : 2 258
Pages: 1
- Accueil forums
- » Le bar
- » Des coronavirus encore inconnus et potentiellement « très dangereux » découverts à Wuhan